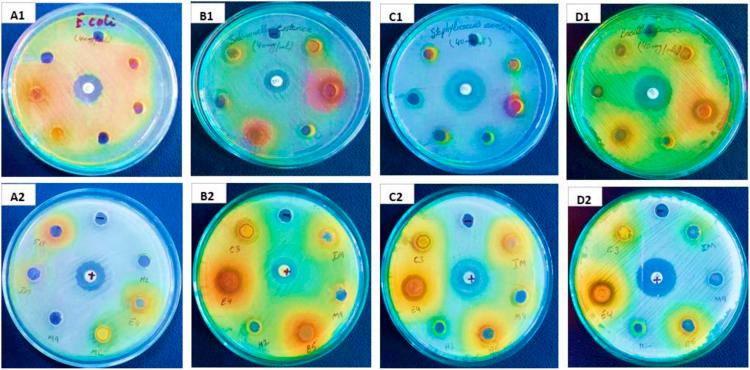

从瓜尔豆中提取和优化活性代谢产物:体外生物学和植物化学研究
Extraction and Optimization of Active Metabolites From Cluster Bean: An In Vitro Biological and Phytochemical Investigation.
作者信息
Riaz Saima, Hussain Iqbal, Ibrahim Muhammad, Ishtiaq Muhmmad, Ali Qasim, Muazzam Ali Muhammad, Sajid Hamid Akash Muhammad
机构信息
Department of Botany, Government College University, Pakistan.
Department of Applied Chemistry, Government College University, Pakistan.
出版信息
Dose Response. 2022 May 7;20(2):15593258221098992. doi: 10.1177/15593258221098992. eCollection 2022 Apr-Jun.
The current study aimed to explore active metabolites of locally recognized and high yielding cultivar cluster bean (BR-99) with a wide range of adaptability having antioxidant, antidiabetic, antimicrobial, and cytotoxic potential. Six solvents were used (crude methanol, n-hexane, chloroform, ethyl acetate, butanol, and aqueous) with escalating polarity for colorimetric determination of antioxidants such as total phenolic contents (TPC), total flavonoid contents (TFC), and free radical scavenging activity (FRSA) by DPPH (2, 2-diphenyl-1-picrylhydrazyl) assay. Moreover, an antidiabetic and anticancer study was conducted by α-amylase inhibition and MTT (3-(4, 5-dimethyl-2-thiazolyl)-2, 5-diphenyl-tetrazolium bromide) assay. Biological investigations were carried out against the most commonly found infectious microbial strains. The significant results (P ≤ .001) of each activity were seen among six tested solvent extracts. The ethyl acetate and methanol extract have more antioxidant potential with the highest TPC (16.38 ± .13 mg GAE/g) and TFC (8.15 ± .24 mg CE/g), respectively. Similarly, methanol extract presented the highest free radical scavenging activity (46.31 ± .91%), followed by ethyl acetate, butanol, chloroform, aqueous, and n-hexane extract. However, the maximum α-amylase inhibition (62.54 ± 1.47%) and anticancer activity against human lung cancer cells were congregated (78.31 ± 1.46%) in butanol and chloroform, respectively. A positive correlation was seen between TPC with TFC ( = .8356), FRSA ( = .8381), and anti-diabetic activity ( = .8082), which highlights the phenolic contents as strong anti-oxidant agents especially flavonoids. Each extract of cluster bean (BR-99) showed significant antimicrobial activities for all tested bacterial strains except and . The profound results of maximum antibacterial activity were witnessed by chloroform extract while ethyl acetate extracts showed great antifungal potential against all tested fungal strains. The HPLC quantitative analysis results of cluster bean (BR-99) revealed the presence of active phytochemicals such as gallic acid, HB acid, vanillic acid, kaempferol, sinapic acid, ferulic acid, salicylic acid, coumarins, quercetin, rutin, p-coumaric acid, and catechin, and the variation in both phytochemical and biological spectrums envisioned the cluster bean (BR-99) used in future as a cheap, safer, and potent source of bioactive drugs.
本研究旨在探索当地公认的高产栽培品种瓜尔豆(BR - 99)的活性代谢产物,该品种具有广泛的适应性,具有抗氧化、抗糖尿病、抗菌和细胞毒性潜力。使用了六种极性递增的溶剂(粗甲醇、正己烷、氯仿、乙酸乙酯、丁醇和水),通过比色法测定抗氧化剂,如总酚含量(TPC)、总黄酮含量(TFC),并通过DPPH(2,2 - 二苯基 - 1 - 苦基肼)法测定自由基清除活性(FRSA)。此外,通过α - 淀粉酶抑制和MTT(3 - (4,5 - 二甲基 - 2 - 噻唑基) - 2,5 - 二苯基 - 四氮唑溴盐)法进行了抗糖尿病和抗癌研究。针对最常见的感染性微生物菌株进行了生物学研究。在六种测试的溶剂提取物中均观察到了每种活性的显著结果(P≤0.001)。乙酸乙酯和甲醇提取物分别具有更高的抗氧化潜力,TPC最高(16.38±0.13毫克没食子酸当量/克)和TFC最高(8.15±0.24毫克儿茶素当量/克)。同样,甲醇提取物表现出最高的自由基清除活性(46.31±0.91%),其次是乙酸乙酯、丁醇、氯仿、水和正己烷提取物。然而,丁醇和氯仿分别对α - 淀粉酶的抑制作用最大(62.54±1.47%),对人肺癌细胞的抗癌活性最高(78.31±1.46%)。TPC与TFC(r = 0.8356)、FRSA(r = 0.8381)和抗糖尿病活性(r = 0.8082)之间呈正相关,这突出了酚类物质尤其是黄酮类化合物作为强抗氧化剂的作用。瓜尔豆(BR - 99)的每种提取物对除 和 之外的所有测试细菌菌株均表现出显著的抗菌活性。氯仿提取物展现出最大抗菌活性的显著结果,而乙酸乙酯提取物对所有测试真菌菌株均显示出强大的抗真菌潜力。瓜尔豆(BR - 99)的HPLC定量分析结果显示存在活性植物化学物质,如没食子酸、HB酸、香草酸、山奈酚、芥子酸、阿魏酸、水杨酸、香豆素、槲皮素、芦丁、对香豆酸和儿茶素,并且植物化学和生物学谱的变化预示着瓜尔豆(BR - 99)未来可作为一种廉价、安全且有效的生物活性药物来源。